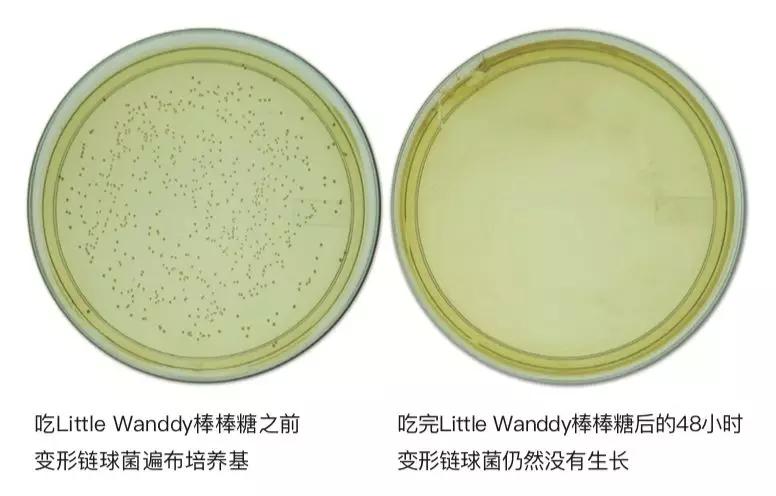
造成蛀牙的细菌有很多种,在这群恶徒中以「变形链球菌」为首.

变形链球菌

变形链球菌
图片尺寸900x500
变形链球菌的细菌
图片尺寸1100x1100
变形链球菌丨wikimedia commons, centers for disease
图片尺寸550x402
变形链球菌
图片尺寸450x285
变形链球菌的细菌
图片尺寸1100x1100
变异链球菌-北纳生物
图片尺寸417x313
变形链球菌照片
图片尺寸450x300
变异链球菌
图片尺寸362x222
一般认为致龋菌有两种类型,一种是产酸菌属,其中主要为变形链球菌,放
图片尺寸900x500
链球菌
图片尺寸268x247
变形链球菌 是口腔天然菌群中占比例最大的链球菌属中的一种,为
图片尺寸500x348
变形链球菌照片
图片尺寸450x300
现实微观医学例证变形链球菌脑膜炎奈瑟氏菌快乐男孩接种疫苗注射或免
图片尺寸400x300
造成蛀牙的细菌有很多种,在这群恶徒中以「变形链球菌」为首.
图片尺寸776x496
变形链球菌拥有非常厚的荚膜,它的存在是导致龋齿的重要因素纵使带了
图片尺寸646x439
导致儿童龋齿的细菌有产酸菌属:变形链球菌,放线菌属,乳杆菌等;革兰
图片尺寸800x346
"是细菌,主要有两种细菌威胁牙齿,一种是产酸菌,其中主要为变形链球菌
图片尺寸800x400
变异链球菌菌落状态及鉴定-1
图片尺寸675x900
嘴里有这样一个垃圾场,没有口臭才怪!
图片尺寸640x371
生物,黑色背景,细菌,摄影,铁环,锁链,链条,束缚,限制,约束,变形链球菌
图片尺寸819x545